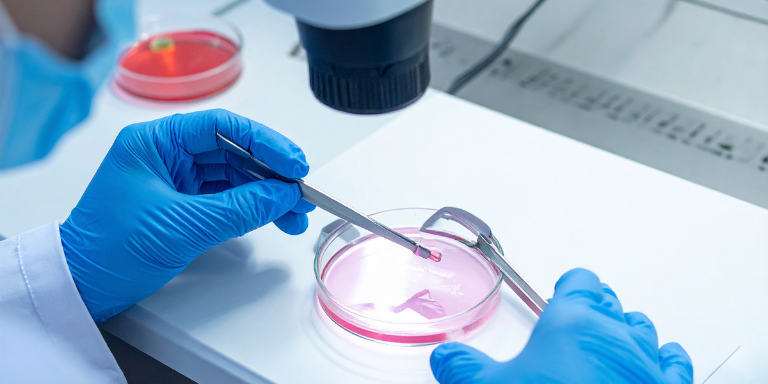
ivf

When it comes to starting a family, modern fertility treatments have made things that once seemed impossible now possible.
Two of the most common options are Surrogacy vs IVF. Both help people and couples become parents, but they work in different ways. Knowing the differences between surrogacy and IVF is important to help you decide which is best for your situation. In this guide, we’ll explain how each of these options works, who might benefit from each, and how to choose the one that fits you best.
What is IVF?
In Vitro Fertilization, or IVF, is a fertility treatment where an egg is combined with sperm in a lab to create an embryo.
Once the embryo is ready, it is placed into the uterus of the intended mother (or the person who will carry the pregnancy).
IVF is often suggested for:
- Women with blocked or damaged fallopian tubes
- Couples who have unexplained infertility
- People with problems releasing eggs
- Men with low sperm count or poor sperm movement
- Women who want to freeze their eggs for future use
Benefits of IVF:
- It allows you to have a biological connection to your child
- It usually has fewer legal issues than surrogacy
- It can be less expensive than surrogacy
- You can freeze embryos for use later
Limitations of IVF:
- The intended mother must carry the baby
- It may take several attempts to be successful
- It can be emotionally and physically taxing
- It’s not suitable for women with serious health or uterine issues
What is Surrogacy?
Surrogacy is when another woman carries and gives birth to a baby for the intended parents.
In most cases, this is called gestational surrogacy, where the surrogate has no genetic link to the child.
Surrogacy might be the right choice if:
- The intended mother can’t carry a baby due to medical reasons
- You’ve had repeated failures with IVF
- The uterus isn’t functioning or isn’t present
- Same–sex male couples want a biological child
- Single men wish to become fathers
Benefits of Surrogacy:
- It offers a way to have a baby when pregnancy isn’t possible
- It can have higher success rates than repeated IVF attempts
- It allows for biological parenthood
- It works for different types of families
Limitations of Surrogacy
- It’s usually more expensive than IVF
- It involves legal agreements and regulations
- It can be emotionally challenging for both the intended parents and the surrogate
- It requires finding a trustworthy surrogate and agency
Key Differences Between Surrogacy and IVF
Understanding the contrast between surrogacy and IVF can make your decision clearer.
- Who Carries the Baby:
IVF: The intended mother carries the pregnancy
Surrogacy: A surrogate carries the pregnancy
- When It’s Needed:
IVF: For people who can carry a baby but havedifficultyconceiving
Surrogacy: For people who can’t carry a baby or it’s unsafe to doso
- Cost:
IVF: Usually more affordable
Surrogacy: More expensive due to medical, legal, and compensationcosts
- Legal Issues:
IVF: Generally has fewer legal steps
Surrogacy: Requires detailed legal contracts and laws to follow
- Emotional Experience:
IVF: Involves the intendedmother in the pregnancy
Surrogacy: Relies on a thirdparty to carry the baby
Choosing between surrogacy and IVF is very personal and depends on several things.
- Medical Condition:
A doctor can help determine if carrying a pregnancy is safe.
A doctor can help determine if carrying a pregnancy is safe. - Money:
IVF can be less costly than surrogacy.
However, if IVF doesn’t work after many tries, surrogacy might be more efficient for some people.
- Emotional Readiness:
Are you okay with going through pregnancy and fertility treatments?
Are you comfortable trusting a surrogate to carry your child?
Both options require emotional strength, but in different ways.
- Legal and Moral Considerations:
Surrogacyinvolves legal agreements to protect everyone involved.
It’s important to understand local laws and work with professionals.
- Time:
IVF can take several cycles, while surrogacy might take time to find the right surrogate.
Think about your schedule and what you expect.
Can IVF and Surrogacy Work Together?
Yes IVF is actually used in most surrogacy processes. The embryo created through IVF is placed into the surrogate’s uterus. So, they don’t work completely separately, but often go hand in hand.
Final Thoughts: Making the Right Choice
When comparing Surrogacy vs IVF: What’s the Right Choice for You? there’s no single answer that fits everyone. IVF is often the first step for many people facing infertility, especially when pregnancy is medically possible. Surrogacy is an option when pregnancy can’t be achieved safely or successfully.
The best choice comes from a mix of medical advice, emotional readiness, and financial planning. Talking with specialists, counselors, and legal experts can help you feel more confident in your decision.
Conclusion
Both IVF and surrogacy are powerful ways to become parents, each with its own advantages and challenges. IVF lets the intended mother carry the baby, while surrogacy offers a way to have a child when that’s not possible. Understanding your personal situation is the key to making the right decision.
In the end, the goal is the same a healthy baby and a happy family. Whether you choose IVF, surrogacy, or a combination of both, you are taking an important step toward making your dream of parenthood a reality.